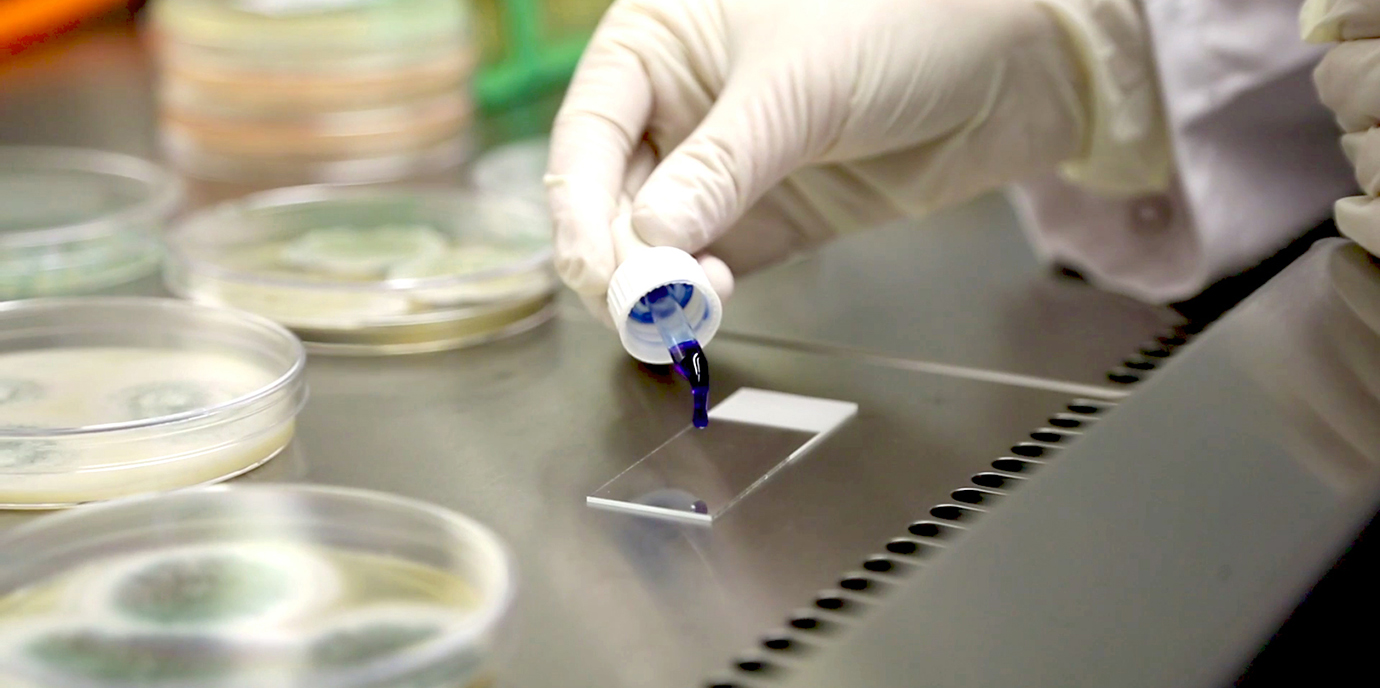
Land Tirol fördert innovative medizinische Forschung

Universitaet
Anerkennung, Repräsentation und Information: Das Med Uni Innsbruck Postdoc Network
19.06.2026 07:37

Forschung
Europäische Chirurg:innen einigten sich in Innsbruck auf Vorgehen bei Leberresektionen
18.06.2026 13:09



Auszeichnung
Event
Silbernes Verdienstzeichen der Republik Österreich für Marco Freek
11.06.2026 07:14



Forschung
Innsbrucker Virologin Gisa Gerold leitet millionenschweres EU-Projekt zu Chikungunya-Impfstoff
02.06.2026 08:32


Auszeichnung
„Wie geht es dir heute?“ App für krebskranke Kinder gewinnt Lohfert-Preis 2026
28.05.2026 09:24







Forschung
NLRP3-Hemmer Dapansutril zeigt vielversprechendes Potenzial für die Therapie von Parkinson und MSA
05.05.2026 13:16

Forschung
Klinik
Hitze gegen Leberkrebs: „Heilung und Rückfall liegen oft im Millimeterbereich“
04.05.2026 10:14

Klinik
Kunst auf der Chirurgie-Baustelle: SOLANGE-Slogan thematisiert mentale Gesundheit von Eltern
29.04.2026 14:50



Klinik
Forschung
Klinikdirektor Ulrich setzt auf interdisziplinäre Zusammenarbeit und Innovationen
16.04.2026 12:54

Menschen
Teach and Study
Typisierungsaktion an der Med Uni: Einsatz aus persönlicher Erfahrung
15.04.2026 13:36


Forschung
Knochenbrüche nach Eisenmangel: Wahl des Eisenpräparats beeinflusst Frakturrisiko
08.04.2026 09:00


Forschung
PredictAYA: Reproduktive Gesundheit von jungen Krebsüberlebenden im Fokus
26.03.2026 10:36